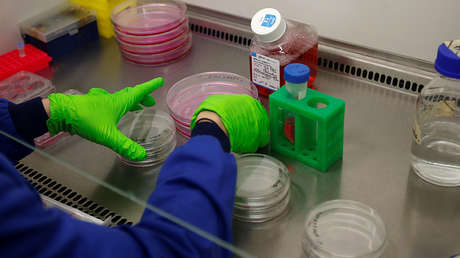
Desarrollan un fármaco que adormece las células cancerígenas

Los científicos australianos del Instituto de Investigaciones Médicas Walter and Eliza Hallde Melbourne han desarrollado un nuevo medicamento contra el cáncer capaz adormecer a las células responsables que evitaría a los pacientes los efectos secundarios dañinos causados por las terapias convencionales, informa MedicalXpress.
Publicado el 2 de agosto en la revista Nature, un artículo explica cómo funcionan estos fármacos que, además de hacer dormir a las células cancerígenas, detienen el crecimiento y la propagación de los tumores sin dañar el ADN de las células.
El novedoso medicamento puede constituir una alentadora alternativa para las personas con cáncer, pues ha demostrado ya ser capaz de detener la progresión de la enfermedad en algunos tipos de leucemia y cánceres de hígado.
La sustancia desarrollada inhibe dos tipos de proteína llamadas KAT6A y KAT6B. Ambas se consideran estrechamente relacionadas con el desarrollo tumoral y son dos de los principales motores de crecimiento de las células cancerosas.
Al aplicar un tratamiento que inhibe la formación de esas proteínas, los investigadores han logrado cuadruplicar la esperanza de vida en animales afectados por linfomas, uno de los tipos de tumor más letales.